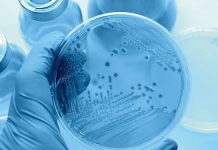
Legionellenwachstum. Foto: Fotolia

Ist Ihre Heizung fit für die Zukunft?
Die Schweiz schreitet vereint der Energie-Effizienz entgegen. Bald werden die «Mustervorschriften der Kantone im Energiebereich», die sogenannten MuKEn 2014, gesamtschweizerisch rechtskräftig. Das Ziel: die...
Energiesystem der Zukunft
In einem gemeinsamen Forschungsprojekt von fünf Schweizer Kompetenzzentren für Energieforschung haben Wissenschaftler des Paul Scherrer Instituts PSI, der Eidgenössischen Materialprüfungs- und Forschungsanstalt (Empa), der...
Smartes Licht. Smarter Taster.
Neu lässt sich das intelligente Beleuchtungssystem Philips Hue nicht mehr nur mit der App steuern, sondern auch mit dem von Feller entwickelten Smart Light...
Mobile Solaranlage für das VBS
Die winsun AG reagiert auf die neusten Pläne des eidgenössischen Departements für Verteidigung, Bevölkerungsschutz und Sport (VBS), in Zukunft auf erneuerbare Energien zu setzen: Das auf...
Energieeffizinez kontra Trinkwarmwasser-Hygiene
Architekten in der Schweiz sind gefordert, aktuelle technische Entwicklungen in ihrer Konzeptplanung zu berücksichtigen. Die Haustechnik-Planer sind sonst hinterher nicht in der Lage, neue,...
Axpo steigt in internationales Solargeschäft ein
Axpo hat einen Vertrag zur Übernahme des französischen Photovoltaik-Unternehmens Urbasolar unterzeichnet. Axpo setzt damit die Wachstumsstrategie im internationalen Geschäft fort. Nach dem Aufbau des...
Energie aus dem See
Der Vierwaldstättersee birgt gewaltige Wärmereserven. Dank diesen ist es zukünftig möglich, in Horw und Kriens mit Seewasser zu heizen. ewl energie wasser luzern setzt...
Wo Sonnenenergie Sinn macht
Seit dem 15. April 2019 zeigt die interaktive Anwendung sonnenfassade.ch für jede Immobilie der Schweiz, wie gut ihre Fassaden für die Nutzung der Solarenergie...
Wasserkraft ist wichtige Energiequelle
Der Strom aus Schweizer Steckdosen stammte 2017 zu rund 68 Prozent aus erneuerbaren Energien: Zu 60 Prozent aus Grosswasserkraft und zu rund 7 Prozent...
Die Fortschrittlichste ihrer Art
Die neuste Generation Wärmepumpen von alpha innotec – die alira NP-AW 20 – ist die fortschrittlichste ihrer Klasse und an Vielseitigkeit kaum noch zu...